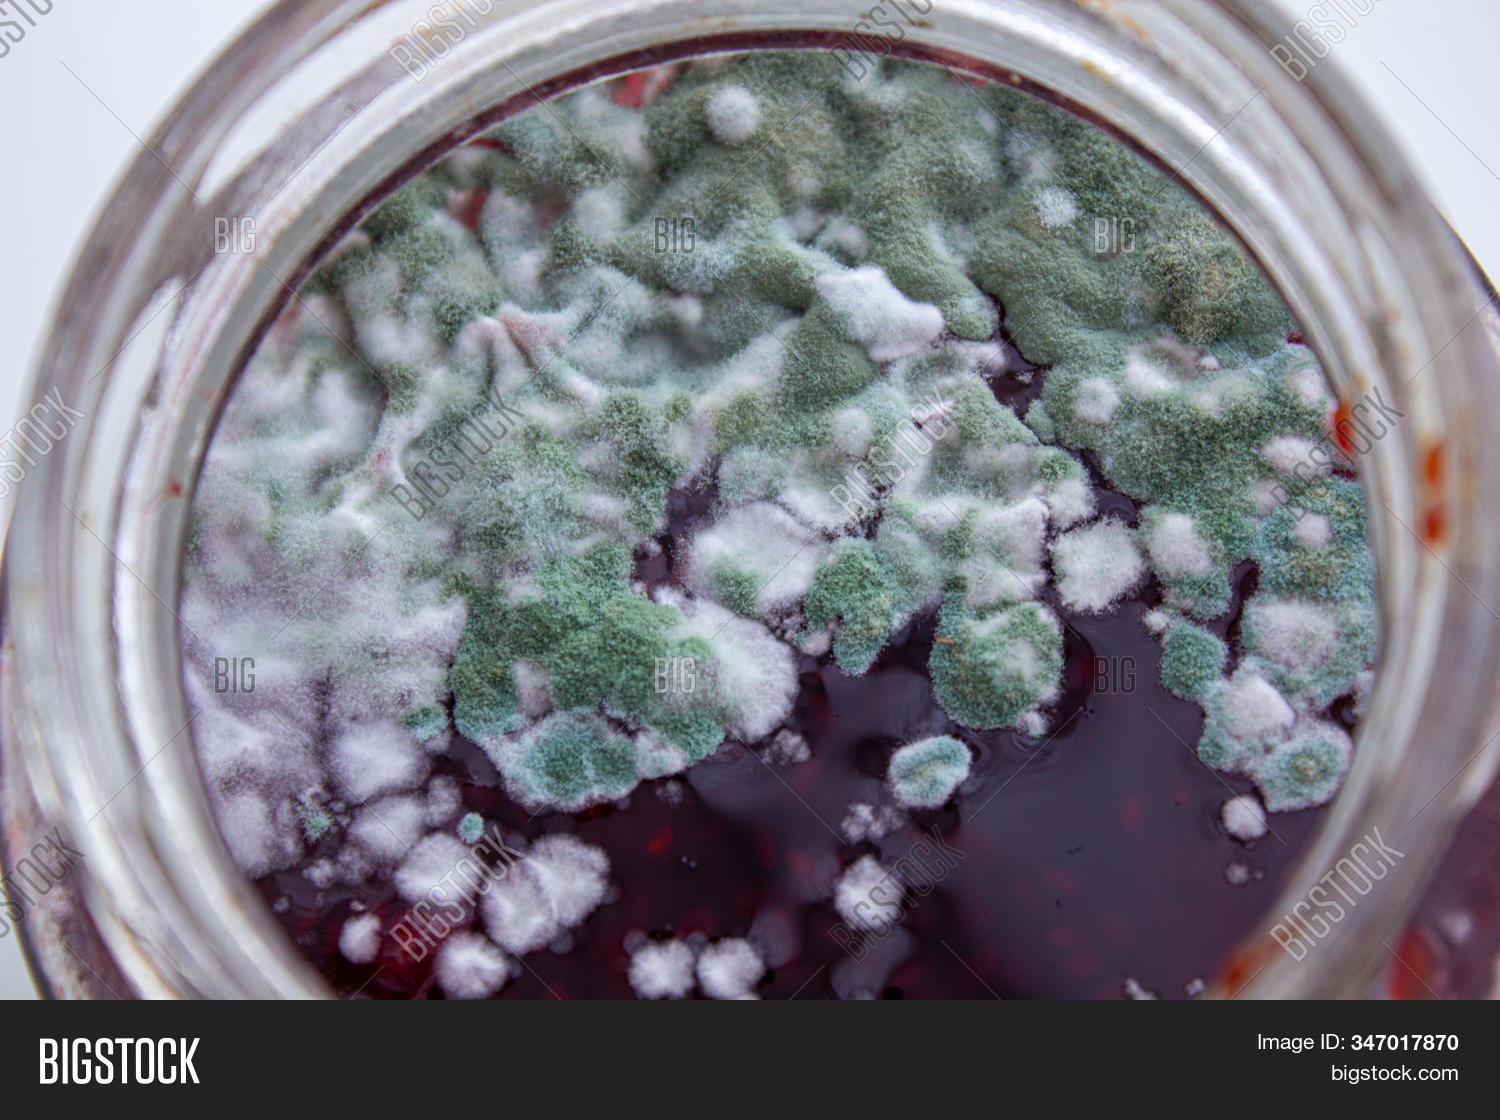

аренье покрывается плесенью
Почему варенье покрывается плесенью 102 фото
Где фармить гамму сталкрафт х
Погода а наволоках
Троекурово яблоки
Hamkorbank telefon
Суперстрой монтажников
Апикальный перелом лодыжки что это
Ногмова 72 нальчик
Ловля гребешка
Ярп 250а у1
Открой входящие сообщения